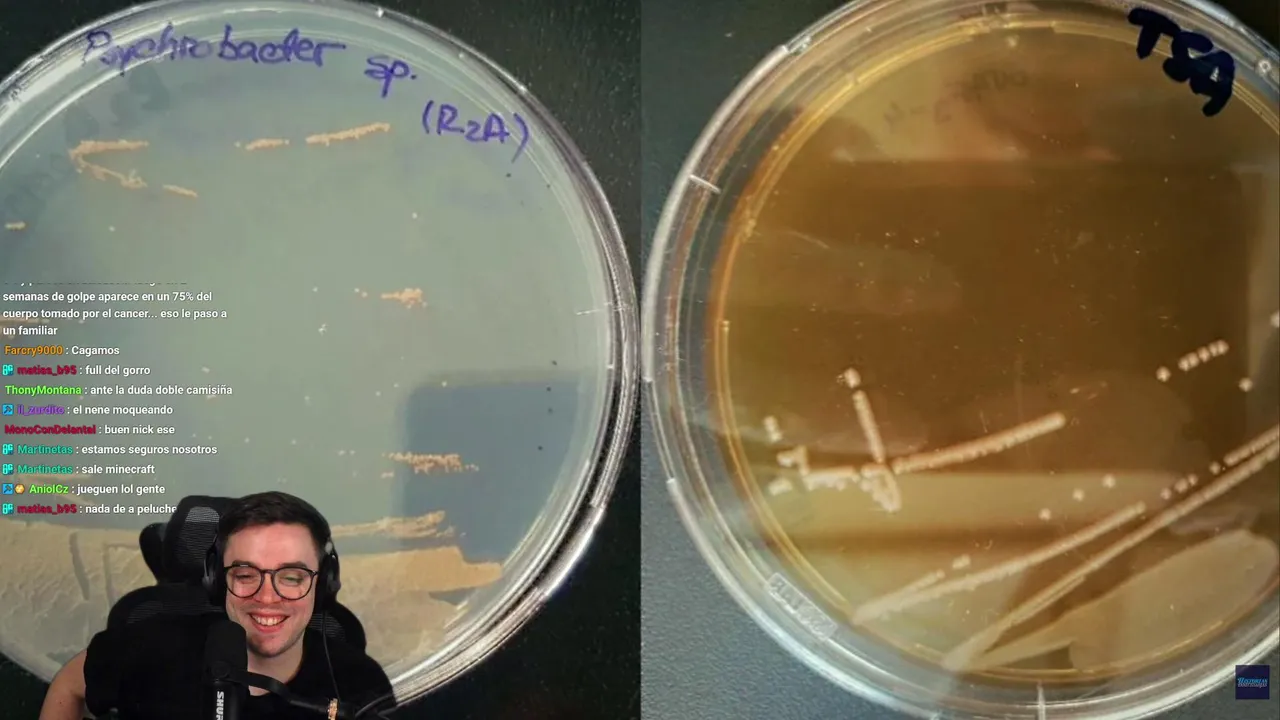

Language
-
401
 Emiru247
on twitch.tv
Emiru247
on twitch.tv
Viewers: 325
Duration: 480 min. -
402
 FranceRugby
on twitch.tv
FranceRugby
on twitch.tv
Viewers: 324
Duration: 64 min. -
403
 Dante_Will
on twitch.tv
Dante_Will
on twitch.tv
Viewers: 323
Duration: 4 min. -
404
Село и Люди on vkvideo.ru
Viewers: 322
Duration: 45 min. -
405
 Kungitto
on twitch.tv
Kungitto
on twitch.tv
Viewers: 322
Duration: 244 min. -
406
 MÌ KAY 🥗🥗🥗
on bigo.tv
MÌ KAY 🥗🥗🥗
on bigo.tv
Viewers: 320
Duration: 185 min. -
407
 Bl8nkp8ge
on twitch.tv
Bl8nkp8ge
on twitch.tv
Viewers: 319
Duration: 377 min. -
408
 jimboz
on kick.com
jimboz
on kick.com
Viewers: 316
Duration: 19 min. -
409
 eltheodoro0
on twitch.tv
eltheodoro0
on twitch.tv
Viewers: 314
Duration: 239 min. -
410
 RuethTV
on twitch.tv
RuethTV
on twitch.tv
Viewers: 314
Duration: 1 min. -
411
 nothingb4kaiyo
on twitch.tv
nothingb4kaiyo
on twitch.tv
Viewers: 314
Duration: 232 min. -
412
 Herr_Currywurst
on twitch.tv
Herr_Currywurst
on twitch.tv
Viewers: 310
Duration: 292 min. -
413
 TheKaterinaLo
on twitch.tv
TheKaterinaLo
on twitch.tv
Viewers: 310
Duration: 244 min. -
414
 Redify
on twitch.tv
Redify
on twitch.tv
Viewers: 309
Duration: 282 min. -
415
우기성 on afreecatv.com
Viewers: 308
Duration: 584 min. -
416
 ✿ɴɢᴏ̂́🦊ᴜ́🥗🥩
on bigo.tv
✿ɴɢᴏ̂́🦊ᴜ́🥗🥩
on bigo.tv
Viewers: 308
Duration: 75 min. -
417
 🌞🤎なるまま
on bigo.tv
🌞🤎なるまま
on bigo.tv
Viewers: 308
Duration: 7 min. -
418
 Linda ᴰᴹ 🌸
on bigo.tv
Linda ᴰᴹ 🌸
on bigo.tv
Viewers: 307
Duration: 40 min. -
419
 🐝➰はち👑hachi💛
on 17.live
🐝➰はち👑hachi💛
on 17.live
Viewers: 306
Duration: 195 min. -
420
 ismatorrr
on twitch.tv
ismatorrr
on twitch.tv
Viewers: 306 -
421
 tinniw
on twitch.tv
tinniw
on twitch.tv
Viewers: 305
Duration: 149 min. -
422
 Alvini98
on twitch.tv
Alvini98
on twitch.tv
Viewers: 302
Duration: 314 min. -
423
 yummy_2
on twitch.tv
yummy_2
on twitch.tv
Viewers: 302
Duration: 129 min. -
424
 TOMMASOeBENEDETTA
on twitch.tv
TOMMASOeBENEDETTA
on twitch.tv
Viewers: 302
Duration: 177 min. -
425
 𝓝𝓪𝓗𝓪𝓡 🦄
on bigo.tv
𝓝𝓪𝓗𝓪𝓡 🦄
on bigo.tv
Viewers: 302
Duration: 406 min. -
426
 Bé 🐐🏝️🍀
on bigo.tv
Bé 🐐🏝️🍀
on bigo.tv
Viewers: 302
Duration: 10 min. -
427
 Vlad_CKA
on twitch.tv
Vlad_CKA
on twitch.tv
Viewers: 300
Duration: 20 min. -
428
 babano7
on kick.com
babano7
on kick.com
Viewers: 300
Duration: 19 min. -
429
 天雪雪
on twitch.tv
天雪雪
on twitch.tv
Viewers: 297
Duration: 51 min. -
430
 小步🍼
on 17.live
小步🍼
on 17.live
Viewers: 296
Duration: 67 min. -
431
 Nieuczesana
on twitch.tv
Nieuczesana
on twitch.tv
Viewers: 295
Duration: 273 min. -
432
 ReenZ
on kick.com
ReenZ
on kick.com
Viewers: 295
Duration: 3 min. -
433
 Banan23YT
on twitch.tv
Banan23YT
on twitch.tv
Viewers: 295
Duration: 74 min. -
434
 lumitalle
on twitch.tv
lumitalle
on twitch.tv
Viewers: 295
Duration: 62 min. -
435
 laninhazpp
on kick.com
laninhazpp
on kick.com
Viewers: 294
Duration: 25 min. -
436
 小敏兒💛
on 17.live
小敏兒💛
on 17.live
Viewers: 293
Duration: 133 min. -
437
 eel_5
on 17.live
eel_5
on 17.live
Viewers: 292
Duration: 28 min. -
438
 PaulinPelivideot
on twitch.tv
PaulinPelivideot
on twitch.tv
Viewers: 292
Duration: 95 min. -
439
 brubuxi
on twitch.tv
brubuxi
on twitch.tv
Viewers: 292
Duration: 23 min. -
440
 👑Careemo Waly👑
on bigo.tv
👑Careemo Waly👑
on bigo.tv
Viewers: 292
Duration: 12 min. -
441
 sigmatiktoker1959
on kick.com
sigmatiktoker1959
on kick.com
Viewers: 291
Duration: 19 min. -
442
 PietSmietTV
on twitch.tv
PietSmietTV
on twitch.tv
Viewers: 291 -
443
 tpk_live
on twitch.tv
tpk_live
on twitch.tv
Viewers: 290
Duration: 119 min. -
444
Дмитрий Кравченко on vkvideo.ru
Viewers: 290
Duration: 123 min. -
445
 •❤꧂ᶜᴿᴬᶻᵞ Nirma
on bigo.tv
•❤꧂ᶜᴿᴬᶻᵞ Nirma
on bigo.tv
Viewers: 290
Duration: 46 min. -
446
 PerriKaryal
on twitch.tv
PerriKaryal
on twitch.tv
Viewers: 289
Duration: 164 min. -
447
 Arteemoov
on twitch.tv
Arteemoov
on twitch.tv
Viewers: 289
Duration: 83 min. -
448
 TV1PB
on twitch.tv
TV1PB
on twitch.tv
Viewers: 288
Duration: 282 min. -
449
 Hoor
on bigo.tv
Hoor
on bigo.tv
Viewers: 288
Duration: 247 min. -
450
 cavernadiplatone
on twitch.tv
cavernadiplatone
on twitch.tv
Viewers: 287
Duration: 89 min. -
451
 FemaChat
on twitch.tv
FemaChat
on twitch.tv
Viewers: 287
Duration: 119 min. -
452
 Lương Thiện
on bigo.tv
Lương Thiện
on bigo.tv
Viewers: 287
Duration: 60 min. -
453
 АНАСТАСИЯ И ГЛЕБ
on bigo.tv
АНАСТАСИЯ И ГЛЕБ
on bigo.tv
Viewers: 287
Duration: 17 min. -
454
 Teosssty
on kick.com
Teosssty
on kick.com
Viewers: 286
Duration: 11 min. -
455
 小雪
on 17.live
小雪
on 17.live
Viewers: 285
Duration: 82 min. -
456
 DedEwgen
on twitch.tv
DedEwgen
on twitch.tv
Viewers: 283
Duration: 24 min. -
457
 teoztwich
on twitch.tv
teoztwich
on twitch.tv
Viewers: 283
Duration: 160 min. -
458
 CastCrafter
on twitch.tv
CastCrafter
on twitch.tv
Viewers: 283
Duration: 7 min. -
459
Profe_Akimbox
on kick.com
Profe_Akimbox
on kick.com
Viewers: 281
Duration: 19 min. -
460
 MiaMakesMusic
on twitch.tv
MiaMakesMusic
on twitch.tv
Viewers: 280
Duration: 54 min. -
461
 JardiStream
on twitch.tv
JardiStream
on twitch.tv
Viewers: 280
Duration: 812 min. -
462
 Extazja
on twitch.tv
Extazja
on twitch.tv
Viewers: 279
Duration: 172 min. -
463
 Kitsunero
on twitch.tv
Kitsunero
on twitch.tv
Viewers: 277
Duration: 118 min. -
464
 卡門哥
on twitch.tv
卡門哥
on twitch.tv
Viewers: 277
Duration: 948 min. -
465
윤아현 on afreecatv.com
Viewers: 275
Duration: 263 min. -
466
 m_a_r_a_h
on twitch.tv
m_a_r_a_h
on twitch.tv
Viewers: 275
Duration: 95 min. -
467
 flyinguwe87
on twitch.tv
flyinguwe87
on twitch.tv
Viewers: 275
Duration: 31 min. -
468
 𝓔𝓵𝓲𝓯𝓯🌼
on bigo.tv
𝓔𝓵𝓲𝓯𝓯🌼
on bigo.tv
Viewers: 275
Duration: 48 min. -
469
 insah_hasni
on twitch.tv
insah_hasni
on twitch.tv
Viewers: 274
Duration: 119 min. -
470
 Samia
on twitch.tv
Samia
on twitch.tv
Viewers: 272
Duration: 10 min. -
471
 SharonQueen
on twitch.tv
SharonQueen
on twitch.tv
Viewers: 272
Duration: 4451 min. -
472
 ShakoMako
on kick.com
ShakoMako
on kick.com
Viewers: 270
Duration: 3 min. -
473
 RodikSama
on kick.com
RodikSama
on kick.com
Viewers: 270
Duration: 13 min. -
474
 gremloe
on twitch.tv
gremloe
on twitch.tv
Viewers: 270
Duration: 184 min. -
475
 元子橘子(➖60k版)
on bigo.tv
元子橘子(➖60k版)
on bigo.tv
Viewers: 270
Duration: 114 min. -
476
 Mayumi
on twitch.tv
Mayumi
on twitch.tv
Viewers: 268
Duration: 260 min. -
477
 سما الحربي ♡
on bigo.tv
سما الحربي ♡
on bigo.tv
Viewers: 267
Duration: 529 min. -
478
 DenzelZockt
on twitch.tv
DenzelZockt
on twitch.tv
Viewers: 266
Duration: 10 min. -
479
 vadushaq
on twitch.tv
vadushaq
on twitch.tv
Viewers: 266
Duration: 62 min. -
480
 YaraskyGaming
on twitch.tv
YaraskyGaming
on twitch.tv
Viewers: 265
Duration: 70 min. -
481
 Fusion88
on kick.com
Fusion88
on kick.com
Viewers: 265
Duration: 3 min. -
482
 LegendSpins
on twitch.tv
LegendSpins
on twitch.tv
Viewers: 265
Duration: 416 min. -
483
 さおりん🏥🌡️17時半
on bigo.tv
さおりん🏥🌡️17時半
on bigo.tv
Viewers: 263
Duration: 24 min. -
484
 Guide🐳 С͟п͟б͟
on bigo.tv
Guide🐳 С͟п͟б͟
on bigo.tv
Viewers: 262
Duration: 56 min. -
485
 shokkiofficial
on kick.com
shokkiofficial
on kick.com
Viewers: 260
Duration: 3 min. -
486
 FelipeFariasTV
on kick.com
FelipeFariasTV
on kick.com
Viewers: 260
Duration: 7 min. -
487
 Wymzi
on kick.com
Wymzi
on kick.com
Viewers: 260
Duration: 7 min. -
488
 toad_anna
on twitch.tv
toad_anna
on twitch.tv
Viewers: 257
Duration: 39 min. -
489
 yizzywes
on twitch.tv
yizzywes
on twitch.tv
Viewers: 257
Duration: 63 min. -
490
 ShizzyDE
on twitch.tv
ShizzyDE
on twitch.tv
Viewers: 256
Duration: 103 min. -
491
 Playdate
on twitch.tv
Playdate
on twitch.tv
Viewers: 255
Duration: 52 min. -
492
 KawaiiTyra
on twitch.tv
KawaiiTyra
on twitch.tv
Viewers: 255
Duration: 127 min. -
493
 EllySteiny
on twitch.tv
EllySteiny
on twitch.tv
Viewers: 254
Duration: 41 min. -
494
VENDETTA ЖЖЕТ on vkvideo.ru
Viewers: 254
Duration: 118 min. -
495
아이빈♥ on afreecatv.com
Viewers: 253
Duration: 373 min. -
496
 Myun
on twitch.tv
Myun
on twitch.tv
Viewers: 253
Duration: 111 min. -
497
 𝐍ᵏ🐈⃤ 𝙹𝚑𝚊
on bigo.tv
𝐍ᵏ🐈⃤ 𝙹𝚑𝚊
on bigo.tv
Viewers: 252
Duration: 11 min. -
498
 POPPA⃤TOMCAT
on bigo.tv
POPPA⃤TOMCAT
on bigo.tv
Viewers: 251
Duration: 26 min. -
499
 on bigo.tv
on bigo.tv
Viewers: 251
Duration: 3287 min. -
500
 ☃︎z☰toàn đầu bếp
on bigo.tv
☃︎z☰toàn đầu bếp
on bigo.tv
Viewers: 251
Duration: 94 min.












